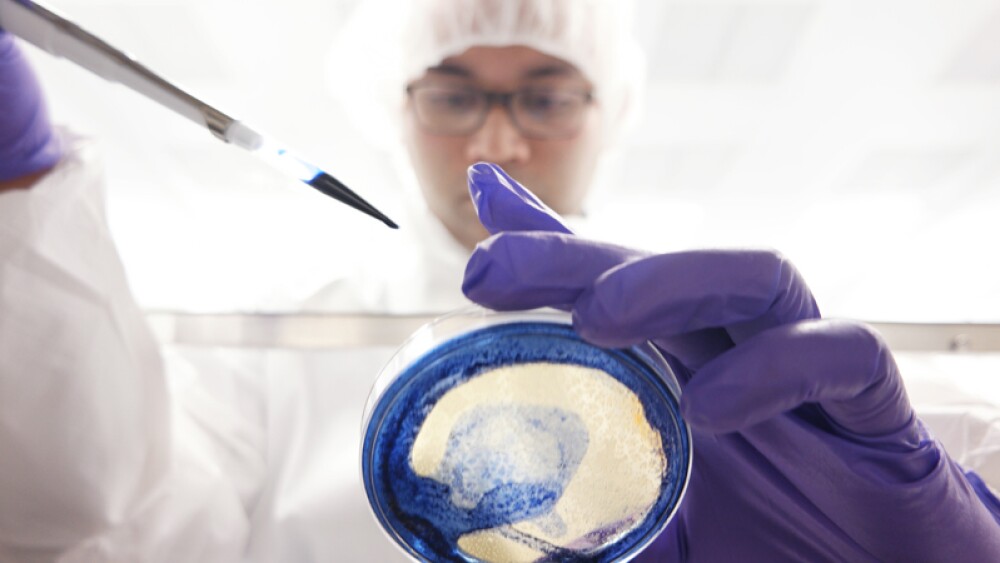
Enumeral Biomedical Gets Evicted as it Winds Down Operations

August 29, 2017
By Mark Terry, BioSpace.com Breaking News Staff
Embattled Enumeral Biomedical was evicted from its Cambridge, Mass. headquarters this week, as it wound down its operations. On August 23, 2017, the company received a letter from its landlord saying its lease was terminated effective immediately.
Enumeral was leasing 16,825 square feet of laboratory and office space at 200 CambridgePark Drive in Cambridge, Mass., the company’s only facility. The lease was for five years with an initial base rent of $42.50 per square feet, or approximately $715,062 per year. The base rent grew over the term of the lease, reaching about $804,739 per year in the fifth year of the lease. Enumeral was also obligated to pay a share of the operating expenses and taxes associated with the site.
The letter indicated that Enumeral did not pay certain parts of rent and other charges due on August 1.
The company has been bleeding cash for at least the last six months. In a May statement, the company said it only had enough funds to continue operations into June 2017. As of March 31, it had cash and cash equivalents of $1.4 million, down from $3.1 million at the end of last year.
The company works on therapeutics for cancer, autoimmune disorders and other diseases. Its lead antibody discovery and development programs targeted checkpoint proteins PD-1, OX40 and Lag3.
In late June, the company announced it had laid off its research-and-development staff. On June 2, it had filed a Prospectus Supplement with the U.S. Securities and Exchange Commission (SEC), that described job cuts and changes to the compensation packages for some of its directors and officers.
On June 9, 2017, it amended the separation letter agreement between itself and Arthur Tinkelenberg, its former president and chief executive officer. In the original Separation Agreement, Enumeral had agreed to make certain payments. Under the amendment, Tinkelenberg “agreed to forego the remaining amounts of the severance payments due to him under the Separation Agreement, effective as of June 1, 2017. In addition, the Company agreed that all remaining unvested options to purchase shares of the Company’s common stock held by Dr. Tinkelenberg fully vest and become exercisable as of June 1, 2017. The Company also waived the non-competition restrictions on Dr. Tinkelenberg under the Separation Agreement.”
On August 14, at the company’s second-quarter financial filings, the company indicated that “it is in the best interests of the Company’s stockholders and creditors to wind down the Company’s remaining operations and effect an orderly disposition of the Company’s remaining assets, including the Company’s intellectual property related to its PD-1 and TIM-3 antibody programs.”
At that time, June 30, its cash and cash equivalents were $576,307. Revenue for the quarter was $189,741. The company indicated that the decrease is attributable to its license agreement with Pieris Pharmaceuticals and a study agreement with Merck (MRK). The company stated, “As the result of the Company’s determinations in June 2017 to terminate its research and development function and sell its laboratory equipment, as well as to wind down its remaining operations, the Company does not expect to conduct any further activities pursuant to its study agreement with Merck. Consequently, the Company does not expect to recognize any additional revenue with respect ot the Merck agreement.”